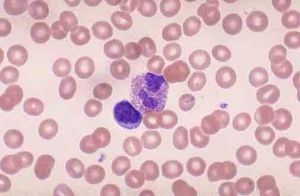
嗜酸性小體 嗜酸性小體

嗜酸性小體
acidophilic body or Councillman body
基本內容
嗜酸性小體:病毒性肝炎時肝細胞胞漿水分脫失濃縮,嗜酸性染色增強,胞漿顆粒消失。如進一步發展,胞漿更加濃縮之外,胞核也濃縮以至消失。最後剩下深紅色均一濃染的圓形小體,即嗜酸性小體。屬於凋亡。需要與嗜酸性小滴鑑別。
嗜酸性變進一步發展,胞漿更加濃縮之外,胞核也濃縮以至消失,最後剩下深紅色均一濃染的圓形小體,即所謂嗜酸性小體。
acidophilic body or Councillman body
嗜酸性小體:病毒性肝炎時肝細胞胞漿水分脫失濃縮,嗜酸性染色增強,胞漿顆粒消失。如進一步發展,胞漿更加濃縮之外,胞核也濃縮以至消失。最後剩下深紅色均一濃染的圓形小體,即嗜酸性小體。屬於凋亡。需要與嗜酸性小滴鑑別。
嗜酸性肉芽腫,是一種孤立性的組織細胞的非腫瘤性質的異常分化。
簡介 臨床表現組織細胞增多病X(histiocytosis X)是由大量增生的染色淡而大的組織細胞在眼眶或全身各臟器軟組織和骨中堆積引起的病變。根據累及的部位不同又分...
概述 病因 臨床表現 分類 診斷病毒性肝炎時肝細胞胞漿水分脫失濃縮,嗜酸性染色增強,胞漿顆粒消失。如進一步發展,胞漿更加濃縮之外,胞核也濃縮以至消失。嗜酸菌研究進展 Advance i...
概述 解釋由肝細胞嗜酸性變發展而來的,細胞質進一步的濃縮,細胞核也濃縮消失,最終形成紅色濃染的圓形小體,為單個肝細胞的死亡,稱為嗜酸性壞死。
嗜酸粒細胞增多症(eosinophilia)是指外周血中嗜酸粒細胞絕對值大於(0.4~0.45)×109/L(400~450/mm3)。臨床上常與多種疾...
病因 發病機制 臨床表現 診斷 治療及預後嗜酸細胞是白細胞的一種,在維持身體正常運行中發揮著極為重要的作用,根據其檢驗值與正常參考值的差異可以初步判斷身體患病情況,因而被廣泛套用於生物學、醫學檢...
基本資料 參考數值 主要作用嗜鹼性粒細胞白血病(basophilic leukemia,BL),1906年Goachim等首次報導,血和骨髓中以嗜鹼性粒細胞為主要成分。患者除有急性...
流行病學 病因 發病機制 臨床表現 併發症風濕小體即阿孝夫小體(Aschoff小體),這是風濕熱特徵性的改變,是確診風濕熱的病理學依據,而且被看作是風濕活動的指標。小體中心有類纖維蛋白樣壞死,周...
症狀 相關 風濕病Councilman bodies,又稱為嗜酸性小體,也可稱為康氏小體。最常見於急性病毒性肝炎。
簡介